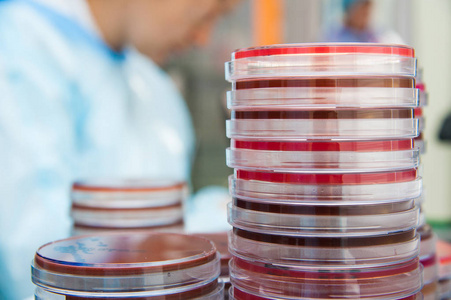
医疗工作台图片-医疗工作台素材-医疗工作台插画-摄图新视界

生物样品

生物样本摄影图__医疗护理_现代科技_摄影图库_昵图网nipic.com
图片尺寸686x1024
biologix生物样本采集管,核酸和采样器,细胞采集管 成都胜拓仪器有限
图片尺寸841x702
生物样品
图片尺寸633x878
关于生物样本库?你应该知道的! - 健康汇
图片尺寸533x386
生物样本摄影图__医疗护理_现代科技_摄影图库_昵图网nipic.com
图片尺寸1024x686
主图标签 科技高清摄影图片下载-主图标签 科技正版摄影图-千图网高清
图片尺寸902x600
#生物样品#植物#动物#超薄切片#透射电镜图片中划圈的到底是 - 抖音
图片尺寸1188x1003
在实验室里处理生物样本的科学家照片-正版商用图片0txt1t-摄图新视界
图片尺寸700x467
生物医药样本库标签-实验动物诊断试剂标签-细胞冻存管低温_苏州盛德
图片尺寸1920x658
血样出库仅需5秒 海尔生物智慧血样管理场景首发_中华网
图片尺寸900x506
医疗工作台图片-医疗工作台素材-医疗工作台插画-摄图新视界
图片尺寸451x300
生物技术样品 :: anton-paar.com
图片尺寸600x300
广州市炳阳生物科技有限公司
图片尺寸655x436
生物样本处理 - 2020年最新商品信息聚合专区 - 百度爱采购
图片尺寸1280x960
"海洋六号"首次采获南极海底生物样品(组图)-新闻中心-南海网
图片尺寸299x450
出厂水微生物检测样品采样规范 - 美篇
图片尺寸1171x856
逗点生物为样本测序前处理提供高通量解决方案 – 逗点生物官方博客
图片尺寸750x750
【干货】扫描电镜生物样品制备技术-微信文章-仪器谱
图片尺寸472x354
tl2700a三目生物显微镜用于微生物样品检测
图片尺寸752x435
#thermo赛默飞冻存管 #nunc生物样本库和细胞培养冻 - 抖音
图片尺寸1440x1654